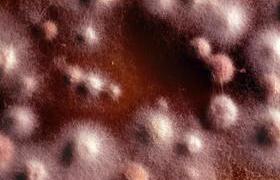

Kwame Nkrumah award for Millar
19 February 2018 | Story Supplied. Photo Supplied. Read time 1 min.
Professor Robert Millar has received the 2017 African Union Kwame Nkrumah Award for Scientific Excellence. This award recognises outstanding scientific achievement and its contribution to Africa’s socioeconomic development. Millar received the award during the African Union Summit in January.
He is a member of UCT’s Institute of Infectious Disease and Molecular Medicine and professor and director of the Centre for Neuroendocrinology at the University of Pretoria.
The Commission of the African Union instituted the award in 2008 in memory of renowned pan-Africanist and first president of the Republic of Ghana, Dr Kwame Nkrumah, who was an ardent supporter of African liberation and unity.
Millar’s recent research focuses on the breakthrough discovery that function can be restored to inactivating mutations in human G-protein-coupled receptors, which are responsible for most cell communication.
This discovery unlocks the possibility for precision, personalised pharmaceuticals that have the potential to treat diseases such as blindness, obesity and diabetes, as well as thyroid, muscle, kidney, reproductive and mental health conditions.
 This work is licensed under a Creative Commons Attribution-NoDerivatives 4.0 International License.
This work is licensed under a Creative Commons Attribution-NoDerivatives 4.0 International License.
Please view the republishing articles page for more information.